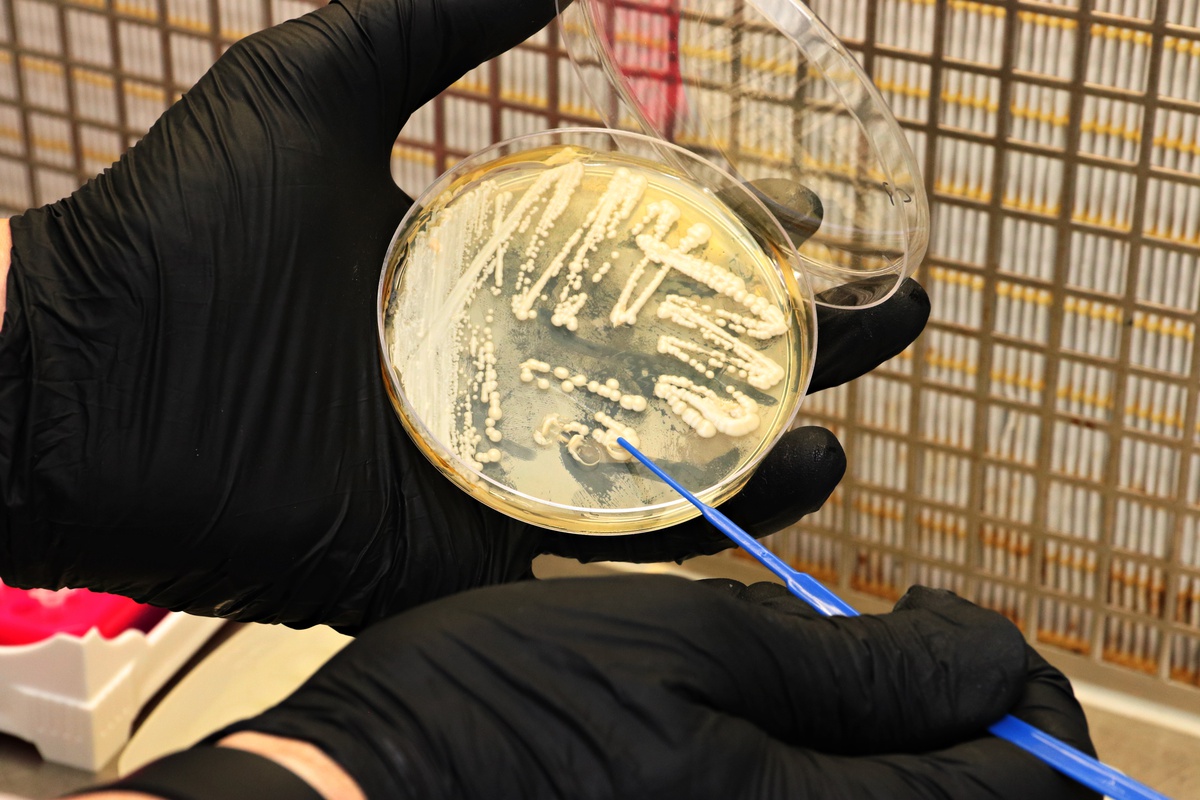

Quem
somos
Al Sukkar é uma empresa que atua em diversos segmentos: na prestação de serviços em análises químicas, microbiológicas, ambientais e no desenvolvimento de produtos de origem biotecnológica. Nosso objetivo é fornecer soluções para obter resultados de análises e parâmetros para o controle do processo, mais rápidos e precisos, propiciando redução de custos e uma melhoria significativa do rendimento industrial. A Al Sukkar surgiu no final de 2008 onde seus sócios se uniram para atender as demandas do mercado nacional e internacional. Desde então a Al Sukkar vem crescendo e ampliando seu mercado de atuação, atendendo os setores sucroalcoleiro, automotivo, alimentício e ambiental.
Nossa Política da Qualidade
A Alsukkar está comprometida em satisfazer os requisitos aplicáveis, com a implementação e melhoria contínua do Sistema de Gestão da Qualidade e das Boas Práticas, satisfação dos clientes, competência dos seus colaboradores, imparcialidade nas atividades e na operação consistente do laboratório.
Missão
Atender com excelência às demandas dos clientes, pelo desenvolvimento e oferta de produtos e serviços que contribuam para a melhoria da qualidade de seus processos industriais, gerando riqueza de forma sustentável.
Visão
A AL SUKKAR visa consolidar-se como uma empresa harmônica e sustentável, criando valores aos seus colaboradores, clientes e meio ambiente.
Valores
A AL SUKKAR está comprometida em proporcionar uma prestação de serviços e análises, que proporcionem a melhor satisfação para os clientes, oferecendo toda a competência dos seus colaboradores, imparcialidade nas atividades, qualidade técnica e na agilidade de atendimento.